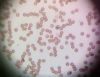

|
|
||||||||||||||||||||||||||||||||
Pēdējie novērojumi
Apodziņš
Glaucidium passerinum - 2026-02-20 Edgars Smislovs
Pelēkā zīlīte
Poecile montanus - 2026-02-20 Алексей
Riekstrozis
Nucifraga caryocatactes - 2026-02-20 Edgars Smislovs
Pelēkā dzilna
Picus canus - 2026-02-20 Edgars Smislovs
Purva zīlīte
Poecile palustris - 2026-02-20 Алексей
Riekstrozis
Nucifraga caryocatactes - 2026-02-20 Edgars Smislovs
Baltmugurdzenis
Dendrocopos leucotos - 2026-02-20 Edgars Smislovs
|
Pēdējie komentāri novērojumiem
Ziemelmeita Vīksna Durkts ja ir kāds imm, tad to norādu. ja nav norādīts - tad visi ad putni. paldies. Te domāts ķērpis? Kāpēc tāds dīvains statuss? ekologs Brūnais garausainis (Plecotus auritus). Vladimirs S Vladimirs S Vīksna ArnitaP 18.februāris, 09:09 Jā, abi putni arī pagājušajā gadā tajā rajonā dzīvoja žurciņš_4 toms.b Vai fonā redzamajam kreves ķērpim varētu noteikt sugu? žurciņš_4 Izskatās pēc Aporia crataegi kūniņas. žurciņš_4 žurciņš_4 VitaS Šis ļoti izskatās pēc Aricia agestis. adata Siona Indulis Martinsons 17.februāris, 17:34 Paldies par Jūsu palīdzību sugas noteikšanā! Indulis Martinsons 17.februāris, 15:52 Osis MJz Trešā no labās izskatās pēc Kanādas zoss. ArnitaP 16.februāris, 17:15 ArnitaP 16.februāris, 16:53 Vai tās varētu būt caunas pēdas? Antarktīda ekologs Lūšu pēdas tās nav. Manuprāt, lapsas pēdas. ekologs Brūnais garausainis (Plecotus auritus). Vīksna Mežirbe777 Hipotētisks Mycocalicium subtile. Būtu jāiegūst papildus objektīvi dati. ArnitaP 15.februāris, 20:29 Vai pēdējais foto, ko pievienoju, kaut ko dod? Vispirms jau pēdām vajadzētu mērogu, lai kaut ko varētu saprast. ArnitaP 15.februāris, 16:47 Vai tās varētu būt lūšu pēdas? Amanda ekologs Te izskatās pēc vidējās spīļastes (Apterygida media). Vīksna ekologs Slaidzirneklis (Pachygnatha degeeri). ekologs Krabjzirneklis (Xysticus cristatus). Vīksna mufunja Paldies, Uldis. Man šķiet, ka tā ir apse. Sintija909 13.februāris, 10:13 Ja tas ir uz apses, varētu būt Punctularia strigosozonata ekologs Tinējs (Apotomis sororculana). ekologs Tinējs (Dichrorampha simpliciana). ekologs Kruzuļzirneklis (Dictyna arundinacea). ekologs Lēcējzirneklis (Attulus terebratus). ekologs ArnitaP 12.februāris, 18:23 mufunja Mežirbe777 ArnitaP 12.februāris, 16:37 Mikroskopēju. Nekā jauna, viss apstiprinās. :) DainisGeo Vīksna Edgars Smislovs Ivars Leimanis Kalnu stāvdivzobe, Orthodicranum montanum (syn. Dicranum montanum) Vīksna ekologs Kāda no sēņmīļiem (latridiidae sp.). ekologs Pēc bildes, izskatās, ka varētu būt Dumbrainis (Cyphon padi). ekologs Zaļais krustazirneklis (Araniella cucurbitina). Vīksna Vīksna Vajadzētu būt tā kā Pterostichus vernalis ekologs Mežirbe777 Vladimirs S Garkaklis vai krīklis, pēc izmēriem varētu noteikt. ekologs Jā, diezgan līdzīgas, ja neieskatās. Ivars Leimanis Vīksna Vīksna finesse ekologs Vīksna Tāds tomēr rets minēts, varbūt cits. Vīksna ekologs Sprakšķis (Synaptus filiformis). pustumsa Oho!! Un cauri mežiņam gar krastu izgājis! Paldies, Andri! Žēl, ka nesatiku! Vīksna ekologs Mīkstspārnis (Cantharis rustica). ekologs ekologs Manuprāt, vientuļā lapsene (Odynerus melanocephalus). ekologs Zebras lēcējzirneklis (Salticus scenicus). adata Šis ir vidējais dzenis, dižraibajam būtu melnā svītra zem vaiga. Zigurds Krievans Vīksna ekologs Nē, Pandemis sugu kāpuriem nav tāda tumša 'apkaklīte'. Kāda cita suga. Vīksna ekologs Teiktu, ka mīkstspārnis (Cantharis pellucida). ekologs Iespējams kāds no Otiorhynchus sp. ekologs Manuprāt, te kārtējā Orchesella flavescens :) ekologs Izskatās pēc tinēja (Pandemis heparana) kāpura. Arī šim nav reģistrējusies vieta. Arī šeit tas pats - kaut kāda sistēmas kļūda bijusi. Vīksna Mikroskopija hipotēzi apstiprināja, paldies par paraugu! :) Toms Čakars mazais_ezis Siona LMM 04.februāris, 23:36 Mežirbe777 Vīksna Tas, ko man likāt atdalīt. Izžuvusi upes gultne ar dažādiem gliemežiem un rokās šī gliemene. adata Viens lieks "t" nosaukumā bija problēma. Bet par sugas pareizību paļaujos uz Jums. Vīksna Antodonta cygnea nevaru pierakstīt. Vīksna ekologs Iespējams, kāda no Pogonognatellus sp. Paldies Ilze! Domāju, ka varbūt Spānis. Pēc foto noteica Arturs Stalažs Pēc foto noteica Arturs Stalažs Pēc foto noteica Arturs Stalažs Pēc foto noteica Arturs Stalažs Pēc foto noteica Arturs Stalažs Pēc foto noteica Arturs Stalažs Pēc foto noteica Arturs Stalažs Pēc foto noteica Arturs Stalažs Pēc foto noteica Arturs Stalažs Pēc foto noteica Arturs Stalažs Pēc foto noteica Arturs Stalažs Pēc foto noteica Arturs Stalažs Pēc foto noteica Arturs Stalažs Pēc foto noteica Arturs Stalažs Pēc foto noteica Arturs Stalažs Pēc foto noteica Arturs Stalažs Pēc foto noteica Arturs Stalažs Pēc foto noteica Arturs Stalažs Pēc foto noteica Arturs Stalažs Pēc foto noteica Arturs Stalažs Pēc foto noteica Arturs Stalažs Pēc foto noteica Arturs Stalažs Pēc foto noteica Arturs Stalažs Pēc foto noteica Arturs Stalažs Pēc foto noteica Arturs Stalažs Pēc foto noteica Arturs Stalažs Vai foto nav? Droši vien arī šoreiz pelēkā. Jānis Ķuze Mežirbe777 Mežirbe777 Physcia caesia (Hoffm.) Fürnr. Vīksna Pēc foto noteica Arturs Stalažs (Arianta arbustorum sadēdējusi čaula) Pēc foto noteica Arturs Stalažs Pēc foto noteica Arturs Stalažs Pēc foto noteica Arturs Stalažs Pēc foto noteica Arturs Stalažs Pēc foto noteica Arturs Stalažs Pēc foto noteica Arturs Stalažs Pēc foto noteica Arturs Stalažs Pēc foto noteica Arturs Stalažs Pēc foto noteica Arturs Stalažs (nepieaudzis Cepaea sp., varētu būt C. hortensis) Pēc foto noteica Arturs Stalažs Pēc foto noteica Arturs Stalažs Pēc foto noteica Arturs Stalažs Pēc foto noteica Arturs Stalažs Pēc foto noteica Arturs Stalažs Pēc foto noteica Arturs Stalažs (Oxychilus sp.) Pēc foto noteica Arturs Stalažs Pēc foto noteica Arturs Stalažs Pēc foto noteica Arturs Stalažs Pēc foto noteica Arturs Stalažs Vīksna Agnese Paldies Edgaram par komentāru! Materiāls ir ievākts un ielikts Dabas muzejas krājumā. Tādu fisciju dabasdatos neatrodu. Cute Kitten 01.februāris, 13:52 Cute Kitten 01.februāris, 12:41 Vai kāds var palīdzēt noteikt vai šis tiešām ir peļu klijāns? Vīksna Vīksna Drīzāk rubiginosa (sevišķi, ja uz kāda ušņ/dadžveidīga Cirisum) Vīksna svilanei 30.janvāris, 13:45 Vai nav tomēr lauku (cik nu tur var redzēt)? Attēlā galva izskatās ļoti dīvainā krāsā... Irbe Matrus Vienu savāca Drauga spārns 28.01.2026. adata Labi, ka tika zem mikroskopa! Samulsināja tie vertikāli pastieptie augļķermeņi. |